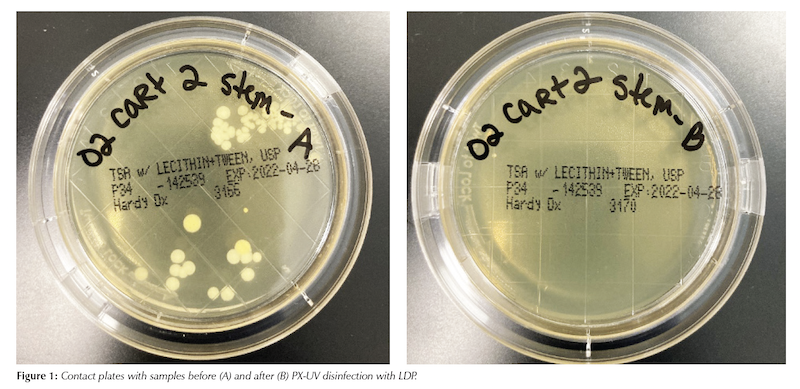

Fuad Ibrahimov, MPH1, Nicole Shum, MPH1, Susan Roman, MD1,2, Sarah Simmons, DrPH3, Danielle James3, and Katie Velasquez, BS3
1Infection Prevention and Control Department, Fraser Health Authority, Surrey, British Columbia, Canada;
2Medical Microbiology, Surrey Memorial Hospital, Surrey, British Columbia, Canada;
3Xenex Disinfection Services Inc., San Antonio, Texas, USA
Corresponding author:
Fuad Ibrahimov
Manager, Evaluation and Quality Improvement
Infection Prevention and Control Department
Fraser Health Authority
400 - 13450 102 Avenue, Surrey, BC, V3T 0H1 Canada
Tel: 604-587-4600 ext. 765932 | Fax: 604-587-4666 | Email: fuad.ibrahimov@fraserhealth.ca
ABSTRACT
Background: The disinfection of portable medical equipment (PME) is a significant challenge in healthcare settings, creating the potential for transmission of healthcare-associated infections (HAIs). A LightStrike Disinfection Pod (LDP) has been developed using UV reflective material, that when paired with pulsed-xenon ultraviolet light (PX-UV) disinfection, allows for a full 360-degree disinfection of PME.
Methods: A selection of PME underwent sampling using contact plates before and after exposure to PX-UV disinfection in the LDP. All studied items were manually cleaned using disinfectant wipes not more than four hours before PX-UV disinfection.
Results: A total of 414 colonies were counted across 50 contact plates prior to PX-UV exposure in the LDP. Only 46 colonies were counted across 50 plates after exposure, resulting in an 88.89% reduction in total bioburden on PME tested.
Conclusion: This study proves the efficacy of LDP paired with PX-UV in disinfection of PME when used as a supplement to manual cleaning. LDP can help to address challenges with disinfection of shared patient care equipment and, therefore, can support efforts aimed at reduction of healthcare associated infections.
KEYWORDS
Ultraviolet germicidal irradiation; disinfection pod; infection prevention; portable medical equipment
INTRODUCTION
Healthcare-associated infections (HAIs) are a serious patient safety concern that may significantly increase patient length of stay, decrease quality of life and impact hospital morbidity and mortality. According to some estimates, about 220,000 patients contract HAIs and more than 8,000 die in Canadian hospitals every year [1]. Numerous studies have demonstrated that environmental contamination plays a significant role in the transmission of HAIs [2-4]. While significant progress has been made to improve terminal cleaning compliance of high-touch surfaces within patient rooms, cleaning and disinfection of portable medical equipment (PME) remains a significant challenge [5-6]. Research has shown that inadequately cleaned equipment may play a significant role as a vector for the transmission of HAIs between patients [7-9]. PME includes “orphan” equipment and devices that, rather than being tied to specific patients, are meant to be shared by nursing staff among multiple patients on the unit consecutively. Common examples of PME include computers on wheels, patient vitals machines and intravenous infusion (IV) pumps. This type of equipment is considered non-critical according to the Spaulding classification system and does not require high-level disinfection or sterilization after each use, which is usually performed at centralized reprocessing units. Non-critical equipment requires low-level disinfection, which is typically done manually in patient care areas using wipes containing detergent and disinfectant products. There is evidence indicating that manual cleaning is often inadequate with up to a half of hospital surfaces left uncleaned following the routine terminal room cleaning [10]. One of the ways to address this gap is to use additional disinfection methods such as ultraviolet light (UV) disinfection.
One of the types of UV disinfection technology used in health care settings is pulsed-xenon ultraviolet (PX-UV) light, which has well-documented biocidal properties [11, 12]. Like other similar technologies, PX-UV disinfection has very limited penetrating capacity and is not very effective on heavily soiled surfaces. Considering this, it is generally not used alone but as a supplement to manual decontamination.
A LightStrike Disinfection Pod (LDP) has been developed with UV reflective material that, when paired with a PX-UV disinfection device, will allow for full 360-degree disinfection of PME. The LDP is meant to be used routinely for PME disinfection on PX-UV implemented hospital units to further minimize the risks of HAI transmission routes. The purpose of this study is to evaluate the efficacy of LDP on microbiological contamination of PME within the real-world hospital setting.
Methods
PME for testing was chosen based on how common it is used in hospital settings as well as its size and ability to stand alone either on wheels or legs, so it could be placed inside of LDP. It consisted of transport chairs, walkers, commode chairs, oxygen carts, tray tables, vitals machines, and IV pumps. PME items were sampled from the clean equipment storage area in one of the largest hospitals in Fraser Health Authority region of British Columbia, Canada. All items were cleaned with disinfectant wipes as per the regular hospital protocol prior to placement in the storage area. The cleaning protocol requires the use of 0.5% ready-to-use accelerated hydrogen peroxide wipes for all PME except for IV pumps, for which 5,000 ppm bleach wipes are employed. The time between manual cleaning and PX-UV disinfection was kept to a minimum and did not exceed four hours to reduce the impact of natural bacterial decay over time on the study results. Sampling and LDP disinfection were performed on two of each item except for tray tables of which only one item was sampled. Prior to exposure, PME were sampled in various high-touch locations utilizing tryptic soy agar (TSA) contact plates (25 cm2; Hardy Diagnostics, Santa Maria, CA). PME were then exposed to PX-UV inside the LDP for five minutes. After the cycle was completed, PME were sampled again in areas adjacent to the original sample as testing exactly the same area is not recommended for contact plates. A total of 50 pre-exposure and 50 post-exposure samples were taken across all PME. Contact plates were allowed to incubate at 36° Celsius in aerobic conditions for 48 hours before being counted. The results were reported as colony forming units (CFU) per contact plate.
The total CFU counts as well as percent reduction in mean contamination following LDP disinfection was calculated for all PME types. Because of the non-parametric data distribution, a Wilcoxon rank-sum test was used. Statistically significant reduction in contamination was determined by a p-value less than 0.05. Statistical analysis was done using Stata (version 17.0; Stat Corp LLC, College Station, TX).
The ethics waiver was obtained from Fraser Health Research Ethics Board as this evaluation did not constitute research involving humans.
Results
A total of 414 colonies were counted across contact plates prior to PX-UV exposure in the LDP. After exposure only 46 colonies were counted, resulting in an 88.89% reduction in total bioburden. Percent reductions can be seen for each PME in Table 1. An example of the samples before and after PX-UV disinfection from one of the surfaces is provided in Figure 1.

After determining sample non-normality, a Wilcoxon matched pairs sign rank test was performed on total counts, as well as by PME. PME that had less than 10 samples were combined, for statistical purposes, into one group labeled “Other”. The Wilcoxon test indicated that out of a total of 50 different pairs, the pre-exposure counts were greater than the post exposure in 40 cases, equal to in nine cases, and less than in one case. The p-value was <0.00001, indicating that the total reduction in bioburden was statistically significant.
Additionally, all PME categories with 10 or more samples (commode chair, IV pump, vital machine), and the remaining grouped category (other) showed significant reductions.
The detailed results by each surface sampled can be found
in Appendix 1.
DISCUSSION
The results of this study, which is the first of its kind in Canada, indicate that exposure to PX-UV light in the LDP as a supplement to regular manual cleaning can significantly reduce the bioburden present on portable medical devices. It is important to mention that there are no universally accepted standards for the allowable levels of microbial contamination of hospital surfaces. One study proposed 2.5 CFU/cm2 for total aerobic colony counts and <1 CFU/cm2 for “indicator” organisms, such as methicillin-resistant S. aureus, as the threshold above which the risk of HAI is increased [13]. Our results for manual cleaning are below the proposed level for total aerobic colony counts. However, there is no evidence from real-world studies showing that meeting the proposed thresholds reduces HAI rates.
Our findings confirm the results of a similar evaluation conducted in Michigan in 2019, which found 93% reduction in the number of recoverable bacteria on PME after PX-UV disinfection using LDP [14]. Conventional application of PX-UV light for equipment disinfection involves placing PME in a separate room where multiple UV disinfection cycles are employed to achieve proper exposure. The key benefit of using LDP is in its ability to ensure 360-degree exposure with a single disinfection cycle, which significantly increases the amount of UV irradiation delivered to target surfaces, thus improving the effectiveness of disinfection. Boyce et al. showed that the log reduction in C. difficile counts from exposure to UV-C light drops from >2-3 to 1-2 to zero when the object is placed at 90° angle, 0° angle and in shaded area relative to the emitting UV-C device, respectively [15]. In addition, the use of LDP may potentially save valuable staff time required for PX-UV disinfection, as multiple cycles would be needed without LDP to ensure all surfaces are properly exposed. Also, finding a spare room to perform UV disinfection can at times be very challenging as many Canadian hospitals often operate at 100% capacity. Given a relatively small footprint of LDP, it can be easily installed in hallways or large rooms without significant impact on workspace and workflow. Another potential application of this technology is disinfection of patient beds and stretchers. Due to safety restrictions, PX-UV disinfection must be performed in unoccupied rooms, which limits its application in multi-bed patient rooms. The size of the existing LDP would need to be increased to accommodate a patient bed, an issue that needs to be explored further.
The main limitation of this study was the fact that its scope was limited to examining the efficacy of LDP in reducing bacterial contamination of PME without assessing its impact on the rate of healthcare associated infections, which is a subject for future research. Also, the study did not measure the impact of LDP on levels of contamination of some epidemiologically important pathogens commonly responsible for HAIs such as methicillin-resistant Staphylococcus aureus, C. difficile, carbapenem-resistant organisms and others.
However, the study proves the efficacy of LDP paired
with PX-UV in disinfection of PME when used in addition to regular manual decontamination. Its application can help busy hospitals that face increased congestion and space challenges to find creative solutions to improve disinfection of shared patient care equipment.
REFERENCES
1. Zoutman, D.E, Ford, B.D., Bryce E, Gourdeau, M., Hebert, G., Henderson, E., Paton S. (2003). The state of infection surveillance and control in Canadian acute care hospitals. Am J Infection Control; 31(5): 266-273.
2. Anderson, D.J., Chen, L.F., Weber, D.J., Moehring, R.W., Lewis, S.S., Triplett, P.F., Blocker, M., Becherer, P., Schwab, J.C., Knelson, L.P., Lokhnygina, Y., Rutala, W.A., Kanamori, H., Gergen, M.F., Sexton, D.J.; CDC Prevention Epicenters Program. (2017). Enhanced terminal room disinfection
and acquisition and infection caused by multidrug-resistant organisms and Clostridium difficile (the Benefits of Enhanced Terminal Room Disinfection study): a cluster-randomised, multicentre, crossover study. The Lancet; 389(10071): 805-814.
3. Weber, D., Rutala, W. (2013). Understanding and Preventing Transmission of Healthcare-Associated Pathogens Due to the Contaminated Hospital Environment. Infection Control & Hospital Epidemiology; 34(5): 449-452.
4. Otter, J.A., Yezli, S., French, G.L. (2011). The role played by contaminated surfaces in the transmission of nosocomial pathogens. Infection Control & Hospital Epidemiology; 32(7): 687-99.
5. Gardner, P., Muller, M.P., Prior, B., So, K., Tooze, J., Eum, L., Kachur, O. (2014). Wheelchair cleaning and disinfection in Canadian health care facilities: “that’s wheelie gross!”. Am J Infect Control; 42: 1173-1177.
6. Peretz, A., Koiefman, A., Dinisman, E., Brodsky, D., Labay, K. (2014). Do wheelchairs spread pathogenic bacteria within hospital walls? World J Microbiol Biotechnol; 30: 385–387.
7. John, A.R., Alhmidi, H., Cadnum, J.L., Jencson, A.L., Gestrich, S and Donskey, C.J. (2018). Evaluation of the potential for electronic thermometers to contribute to spread of healthcare-associated pathogens. Am J Infect Control; 46: 708-710.
8. Bernards, A., Harinck, H., Dijkshoorn, L., Van der Reijden, T and Van den Broek P. (2004). Persistent Acinetobacter baumannii? Look Inside Your Medical Equipment. Infection Control & Hospital Epidemiology; 25: 1002-1004.
9. Suwantarat, N., Supple, L.A., Cadnum, J.L., Sankar, T and Donskey CJ. (2017). Quantitative assessment of interactions between hospitalized patients and portable medical equipment and other fomites. Am J Infect Control; 45: 1276-1278.
10. Carling, P., Parry, M., Von Beheren, S. (2008). Identifying Opportunities to Enhance Environmental Cleaning in 23 Acute Care Hospitals. Infection Control & Hospital Epidemiology; 29(1): 1-7
11. Stibich, M., Stachowiak, J., Tanner, B., Berkheiser, M., Moore, L., Raad, I., Chemaly, R. (2011). Evaluation of a Pulsed-Xenon Ultraviolet Room Disinfection Device for Impact on Hospital Operations and Microbial Reduction. Infection Control & Hospital Epidemiology; 32(3): 286-288.
12. Jinadatha, C., Quezada, R., Huber, T.W., Williams, J.B., Zeber, J.E., Copeland, L.A. (2014). Evaluation of a pulsed-xenon ultraviolet room disinfection device for impact on contamination levels of methicillin-resistant Staphylococcus aureus. BMC Infectious Diseases; 14: 187.
13. Dancer, S.J. (2004). How do we assess hospital cleaning? A proposal for microbiological standards for surface hygiene in hospitals. Journal of Hospital Infection; 56 (1): 10-15.
14. Reid, D., Ternes, K., Winowiecki, L., Yonke, C., Riege, B., Fregoli, F., Passey, D., Stibich, M., Olmsted, R.N. (2020). Germicidal irradiation of portable medical equipment: mitigating microbes and improving the margin of safety using a novel, point of care, germicidal disinfection pod. Am J Infect Control; 48: 103-105.
15. Boyce, J.M., Farrel, P.A., Towle, D., Fekieta, R., Aniskiewicz, M. (2016). Impact of room location on UV-C irradiance and UV-C dosage and antimicrobial effect delivered by a mobile UV-C light device. Infection Control & Hospital Epidemiology; 37(6): 667-72.


